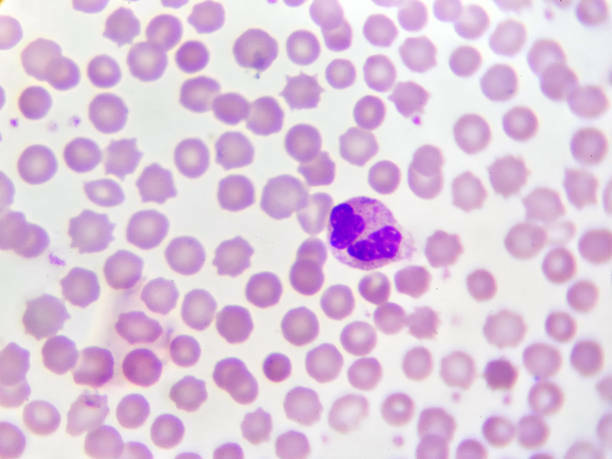
theory

-
 hooke publishes micrographia, micrographia is sketches of various natural things under a microscope. its important because its the first work on microscopy.
hooke publishes micrographia, micrographia is sketches of various natural things under a microscope. its important because its the first work on microscopy. -
 van leeuwenhoek sends letter to royal society that the particles seen under a microscope are living organisms. this is important because this was apart of the first test.
van leeuwenhoek sends letter to royal society that the particles seen under a microscope are living organisms. this is important because this was apart of the first test. -
 achromatic microscopes were introduced
achromatic microscopes were introduced
it was designed to control the effects of chromatic distortion or aberration and to bring focus of all colors to the same convergence point -
 Robert brown recognized the nucleus as an essential constituent of living cells
Robert brown recognized the nucleus as an essential constituent of living cells
the nucleus is the important structure in a cell, it serves the function of information storage. -
 schleiden and schwann discover plants and animals are made of cells, respectively. cell theory formulated
schleiden and schwann discover plants and animals are made of cells, respectively. cell theory formulated
cells are the basic building blocks of all living organisms -
a number of scientists refute "free cell formation" theory.
a number of scientists refute "free cell formation" theory.
is a process of new cell formation found only in ascomycetes. -
 microscopy greatly improved.
microscopy greatly improved.
this is important because there's more small details that scientist will be able to see that they couldn't before. -
 Golgi develops "black reaction" to observe nerve cells.
Golgi develops "black reaction" to observe nerve cells.
this allowed scientists to stain and view the structure of neurons. -
 Wilhelm forwards his idea that the nerve-cell body and its prolongations form an independent unit. the neurons cell body is called the some this is important because most of protein synthesis occurs here
Wilhelm forwards his idea that the nerve-cell body and its prolongations form an independent unit. the neurons cell body is called the some this is important because most of protein synthesis occurs here -
 Waldeyer introduces the term "neuron", paving the way for "neuron theory". the neuron theory is the nervouse system
Waldeyer introduces the term "neuron", paving the way for "neuron theory". the neuron theory is the nervouse system
Looking for a timeline maker?
Create timelines for projects, roadmaps, history, lessons, legal cases, and stories with Timetoast. Timetoast is a timeline maker for work, school, research, and stories.